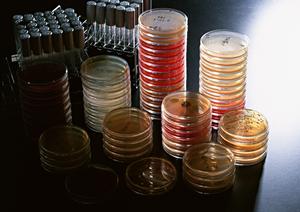

「医療施設について」記事一覧
-
- 安心して通える産婦人科クリニックの選び方とポイント
- 妊娠や出産に関する健康管理や悩みに専門的なアドバイスが必要な際、品川エリアにある産婦人科のクリニックを検索することは一般的です。これまでの経験から、品川エリアにある安心して通...

-
- 歯科医院選びのポイントと土曜診療情報!【札幌】ホワイトニング効果を実感する方法
- 札幌で歯のホワイトニングをお考えの方に向けて、効果的な情報を提供いたします。札幌におけるホワイトニング施術は、自己イメージを向上させるために重要です。ホワイトニング効果を即座...
-
- 新宿エリアの最新医療情報!ワクチン接種に関するクリニック選びのポイント
- 新宿エリアにお住まいの方々にとって、最新の医療情報やワクチン接種に関する情報は非常に重要です。新宿で夜間診療が可能なクリニックをお探しの方や、新型コロナワクチン接種について知...
-
- 新宿エリアで予約が取りやすい内科クリニックを徹底比較!待ち時間少なく通いやすいおすすめの病院をご紹介します
- 新宿エリアで予約が取りやすく、待ち時間が少ない内科のクリニックを探している方にとって、信頼できる情報を提供することは非常に重要です。そこで、新宿三丁目に位置する内科クリニック...
-
- 東京で心療内科治療を受けるなら!専門的な方法でストレス解消をサポートするクリニックを徹底解説
- 東京都内で心療内科の治療を受けたい方にとって、信頼できるクリニックを見つけることは非常に重要です。お忙しい方や交通の便が良くない方にとっては、通いやすい場所にあるクリニックを...

-
- 負担軽減のインプラント治療なら小平で
- 何も人間に限ったことではないけれど、何か物を噛むという行為は生命維持にとって重要な意味を持っています。生きているからは食べなければなりません。そのために必要になるのが丈夫な歯...
-
- 清水区で長期的に歯科に通う時の注意点
- 清水区の歯科医院で最後に自身の生活環境に合った選ぶためには批評や評判を調べることも有効です。ラップトップ上の口コミサイトやSNSなどで他の診察者の意見や体験談を参考にします。...

-
- 三宮エリアで評判の良い小児矯正歯科を徹底比較!
- 三宮エリアでお子さまの歯並びに関するお悩みを解消するために、小児矯正治療を受けることを考えている方々への情報提供を行います。歯並びはお子さまの健康と自信に直結する重要な要素で...

-
- 副鼻腔炎の専門家が教える!八尾市で効果的な治療法と予防方法
- 八尾市にお住まいの方や副鼻腔炎に悩む方々へ向けて、専門的な情報を提供いたします。副鼻腔炎は、副鼻腔の粘膜が炎症を起こす疾患であり、鼻づまりや頭痛などの症状を引き起こすことがあ...

-
- アクセスが簡単で清潔な東海市の歯科
- 衛生管理が行き届いていて、清潔な院内環境で歯科治療を行うことが可能なのが東海市から行けるこの歯医者です。地域の敗者として評判が非常に高くて、多くの人に対して既に多くの実績を与...

-
- 歯の美容と健康を考えるなら必見!北新地エリアの歯医者で叶える最高の治療体験
- 歯の健康を保つためには、定期的な歯科検診が欠かせません。特に、歯周病や虫歯などの予防には、信頼できる歯医者を見つけることが重要です。そこで、北新地エリアで優れた歯医者を探して...

-
- 眼科医院選びのポイントとは?足立区で信頼できる眼科医院を見つける方法
- 東京都足立区にお住まいの方々にとって、眼科医院の選び方は重要な課題となります。眼の健康に関する問題が発生した際、足立区内にある信頼できる眼科医院を見つけることが急務となります...
-
- 歯科インプラントの最新トレンドと痛み軽減治療法を徹底解説
- 歯のインプラント治療は、歯科分野の中でも注目を集めている治療法の一つです。インプラント治療は、失った歯を補うために人工の歯根を埋め込む方法であり、見た目や機能性を高い水準で取...

-
- 梅田の心療内科で早めに治療を受けよう
- 精神疾患を抱える人が増えていることが社会問題になっています。仕事のプレッシャーや人間関係が上手くいっていないことが要因でストレスが溜まってしまい、うつ病などを発症するケースが...
-
- ストレス社会を生き抜く!西新宿の呼吸器内科クリニックで健康管理を始めよう
- 西新宿で呼吸器内科を受診する際に重要なポイントを知っておくことが、健康管理の一環として役立ちます。西新宿地区には多くのクリニックや病院がありますが、その中でも呼吸器内科を専門...

-
- 目に優しい緑内障治療を堺市で始める
- 視界の一部がボヤけたり欠けるような症状が起きたら、緑内障を患っている可能性を考えて早急に検査を受けなければ、視野の欠損が悪化するリスクがあります。堺市にある三木眼科クリニック...

-
- 天然の髪のように自然な医療用かつら
- ウィッグを使っている方は、できれば自分がかつらを使っているということを気づかれたくはないものでしょう。でもやはりウィッグはそれなりの品質で遠くで見て気づかなくても、近づいてみ...

-
- 甲子園駅周辺でアクセス便利な内科クリニックを探している方へ!循環器内科や老年内科の専門医に相談したい方必見の最新医療情報と診療予約方法
- 西宮で利用できる優良な内科クリニックをご紹介します。内科は身近な病気や健康管理に特化した診療科目であり、日常的な体調不良や健康相談に対応しています。特に40代?60代の男性に...
-
- 特殊な薬剤で白くできる日本橋の歯科治療
- 審美性を高めるためにホワイトニングという手段は、とても有効活用されています。ただ、実際にこの手段を用いる場合には本当に口腔内に負担が生じないかということを必ず確認しなくてはい...

-
- 家族全員の歯の健康をサポート!桶川市の歯科クリニックが提供する充実治療サービス
- 桶川市にお住まいの方々が歯科治療を受ける際に重要とされるポイントをご紹介します。桶川市には、歯科治療を受けるためのさまざまな施設やサービスが利用できるため、自身や家族の歯の健...
-
- 健康管理に役立つ最新情報をお届け!
- 健康管理において重要なのは、定期的な内科クリニックの受診です。その中でも、高輪内科クリニックは信頼できる選択肢と言えます。高輪内科クリニックは、熟練の医師陣が患者一人ひとりに...

-
- 京都で通いやすい矯正歯科を徹底解説!詳しい治療内容や費用、アフターケアもご紹介
- 美しい歯並びは、自信を持って笑顔を見せるために欠かせない要素です。しかし、歯並びや噛み合わせの問題を抱えている方は多く、その解決方法として矯正歯科が注目されています。特に京都...

-
- 不育症の原因と対策について知りたい方へ、札幌市の信頼できる医療機関をご紹介します!
- 札幌市で不育症に悩む方々にとって、信頼できる医療機関の選択は非常に重要です。そこで、札幌市にある「ペルル女性クリニック」をご紹介します。ペルル女性クリニックは、不育症の原因と...

-
- 坂戸市で信頼できる歯科医院を見つける方法をご紹介!
- 歯の健康を守るために、信頼できる歯医者を見つけることはとても重要です。坂戸市には多くの歯科医院がありますが、自分に合った歯医者を見つけるためにはいくつかのポイントを押さえる必...

-
- 妊婦健診を受けられる田町駅周辺のクリニックを徹底比較!
- 田町駅周辺で妊婦健診を探している30代女性の主婦の皆さん、安心して通える妊婦健診クリニックをお探しですか?田町駅周辺には、妊婦健診を行っている多くのクリニックがあります。土日...
-
- 女性に嬉しい!安心と信頼の京都の産婦人科で受ける最高品質な診療とサービス提供
- 京都で産婦人科を探している方々にとって、信頼性や安心感が最も重要な要素となります。そこで、京都で信頼できる産婦人科を見つけるためのポイントをご紹介します。1. 医師の経験と専...
.jpg)
-
- 新宿の心療内科で強迫観念の相談
- 強迫観念は精神的な症状の一種であり、その特徴は非常に重要です。強迫観念はしばしば不安障害や強迫性障害と関連があり、以下にその特徴を詳しく説明します。まず強迫観念は不快でしばし...
-
- 子供から通える浜松市の矯正クリニック
- 歯並びが悪いことをコンプレックスに感じているなら、歯並び矯正を受けてみませんか。歯並びの悪さは見た目だけでなく、歯磨きのしやすさなども改善されるため歯の健康にも良い影響がある...

-
- 【東京で心療内科を探している女性必見】信頼できるクリニックの特徴とアクセス情報
- 心療内科を探している東京在住の皆さんにおすすめのクリニックを紹介します。心療内科は心の健康をサポートするための専門医療機関であり、ストレスや不安、うつ病などの精神的な問題を診...

-
- 博多駅そばの歯科はアクセスの良さも特徴
- このWebサイトは、福岡県福岡市博多区の歯科クリニックの公式サイトです。2019年に当地に開業したこの歯科クリニックでは、矯正治療とホワイトニングに特に力を入れています。矯正...
-
- 五反田のクリニックでインプラント治療
- 五反田のクリニックで提供されるインプラント治療は、歯の健康を維持しながら進行性の歯損失に対処する画期的な方法です。私たちの治療では、患者様の歯科健康を最優先に考え、歯を削るこ...

-
- 三軒茶屋で快適なマウスピース矯正治療を受けられる歯科クリニックのご紹介
- 三軒茶屋でマウスピース矯正を考えている方にとって、理想的な選択肢となる矯正治療をご紹介します。マウスピース矯正は、金属ブラケットを使用せずに透明なプラスチックのマウスピースを...

-
- 予防歯科の専門医がオススメ!大和田町周辺の通いやすい歯科医院を徹底解説!
- 大和田町周辺で予防歯科を受ける際のポイントをご紹介します。予防歯科は、歯の健康を保つために非常に重要な役割を果たします。歯のトラブルを未然に防ぐことで、痛みや歯の機能低下を防...
-
- 産婦人科で安心して通える京都のクリニックを徹底比較!最新治療情報と口コミ評価をご紹介
- 京都で産婦人科を探している方々にとって、信頼できるクリニックを選ぶことは非常に重要です。安心して妊娠・出産を迎えるためにも、専門的な知識と経験豊富なスタッフによる対応が求めら...
-
- 循環器内科の専門医がいる沖縄の病院を徹底比較!診療内容やアクセス情報も紹介します
- 沖縄で循環器内科を探している方々にとって、信頼性の高い医療機関を選ぶことは非常に重要です。そこで、沖縄で評判の良い循環器内科クリニックである中村内科クリニックをご紹介します。...
-
- 広尾で通いやすいインプラント治療を提供する歯科クリニックのご紹介
- 広尾でインプラント治療を受けるなら、広尾デンタルクリニックがおすすめです。広尾デンタルクリニックは、高品質な治療を提供する専門的な知識と技術を持った医師によるクリニックです。...
-
- 適切な治療法を提案する札幌の歯科医院
- 札幌市の「スマイルオフィスデンタルクリニック西野本院」では、コミュニケーションの重要性・低侵襲な歯科治療をコンセプトに掲げており、インプラント治療のスペシャリストでもある院長...

-
- ストーマでの入浴で気を付けたいポイント
- ストーマを使った入浴の際には、お湯の温度に注意することです。熱すぎるお湯は皮膚を刺激する可能性があるため、ぬるめのお湯を使うか、医師の指示に従って適切な温度を調整することにな...

-
- 吹田市の内科でアレルギー性鼻炎の治療
- アレルギー性鼻炎は多くの人々に影響を与える一般的な疾患であり、その特徴は次のようにまとめることができます。まず、アレルギー性鼻炎はアレルギー反応によって引き起こされるため、特...

-
- 福利厚生が整っている浜松市の歯科
- 安心して仕事をしたいと考えている人にとって、浜松市のこの歯科はとても人気です。ここでは、福利厚生がしっかりとしていますので、正社員はもちろんですがパートなどで働きたいと考えて...
-
- 不妊症とコンプライアンスへの理解
- 子供を授かることができない人が不妊症だと疑いをもって病院に行くこともありますが、実際に専門的に検査を受けるまで平均で3年以上が掛かるケースが多いです。この理由としては、夫婦間...

-
- 新栄の歯医者は交通アクセスや設備で選ぶ
- 歯に関するトラブルは誰であっても起こりうることであり、早急な治療が必要です。しかし、歯医者はコンビニ並みに数が多くどういった基準で選ぶべきか迷うことが少なくありません。まず考...

-
- 金沢市でドライアイを治療できる
- ドライアイは目が乾いてしまう症状により、炎症を起こしたり視界が霞んでしまうなどの影響が出ることがあります。健康な状態の目には適度に涙が供給されることで常に潤っているのと同時に...

-
- 金沢市の眼科でコンタクトの処方
- コンタクトの処方は個々の目の状態に合わせてカスタマイズされる重要なプロセスです。眼科医の診断と処方箋に基づいて、最適なコンタクトレンズが提供されます。まず専門の眼科医が患者の...

-
- 山口市の入れ歯製作に定評のある歯医者
- ひで歯科クリニックは、山口市にある一般歯科、矯正歯科、ホワイトニングなど幅広い診療を提供している歯医者です。なかでもコンフォート入れ歯、スマートデンチャーなどの入れ歯製作に定...
-
- 小平小児歯科で子供の歯の健康を守ろう
- 小平スマイル歯科クリニックは、東京都小平市小川東町2丁目のイオンフードスタイル小平店の中にある土曜日曜も診療を行ってくれる便利な歯科医院です。休診日は木曜日と祝日のみで、平日...

-
- 矯正治療に力を入れている小平市歯医者
- 小平スマイル歯科クリニックは、虫歯や歯周病の治療、ホワイトニング、インプラントなど幅広い治療を提供している小平市歯医者です。特に歯並びをきれいにするための大人向けの成人矯正、...

-
- 朝霞市の眼科で白内障の治療を受ける
- 白内障は眼の水晶体が濁ってしまい、視界がぼやける状態を指します。これは通常加齢による変化が主な原因ですが、外傷や糖尿病などの要因も影響を及ぼすことがあります。主な特徴は徐々に...
-
- 学芸大学の歯医者での入れ歯治療
- 歯医者での入れ歯治療は、多くの人にとって重要な健康ケアの一環です。入れ歯は、欠損した歯を置き換え、咬合機能や話す能力を回復させ、自信を取り戻すための貴重な選択肢です。入れ歯治...

-
- 泌尿器科疾患は恥ずかしがらないで受診を
- あおば江田クリニックは、神奈川県横浜市青葉区で開業している泌尿器科の診察に力をいれているクリニックになります。患者様のQOL(クオリティオブライフ)の向上に寄与することを目指...

-
- 薬院駅南出口から歩いて7分の歯医者
- 薬院駅南出口から歩いて7分の友枝歯科クリニック平尾は、福岡市中央区の通いやすい歯医者です。矯正歯科や審美歯科の実績が豊富で、患者の幅広い悩みに対応しています。セラミック治療や...
-
- 無痛分娩の実績が豊富な熊本の病院
- 熊本県熊本市「北くまもと井上産婦人科医院」は、産科や婦人科などを診療科目とするクリニックです。産科では妊婦検診や分娩、無痛分娩や母乳外来などの診療を行っています。交通アクセス...

-
- マウスピース矯正できる練馬の歯科医院
- 練馬にあるこちらの歯科クリニックでは、歯の矯正治療に力を入れています。歯並びが悪いと、どうしても見た目が悪くなってしまいますから、なんとかしたいと思っている人が多いのではない...
-
- 目黒区で目立たない歯列矯正治療を受ける
- 目黒区にある「三軒茶屋矯正歯科クリニック」は、歯並びを改善する歯列矯正治療に特化した歯医者さんです。専門医による治療を受けられるので、安心して歯列矯正治療を受けることができま...

-
- 春日井市にある風邪を治す内科があります
- 季節の変わり目に起こる風邪の症状や睡眠不足になってしまう不眠症、糖尿病や高血圧に見られる生活習慣病を治すには内科を受診して診断をしてもらいます。年齢によっては風邪だからと侮っ...

-
- 梅田で心療内科を探しているなら
- ひどい月経困難症や黄体期のPMSや排卵日の体調不良や安定しない生理周期や出産に伴う薄毛・肝斑・骨盤の歪みなど、女性の人生はホルモンバランスに振り回されていると言っても過言では...

-
- 吹田市内にある不妊治療専門の医療機関
- 大阪府吹田市豊津町の医療法人ウェルビーなかむらレディースクリニックは不妊治療を専門に行う医療機関で、顕微授精や卵管鏡下卵管形成術などといった高度生殖医療を行うための設備が整っ...

-
- 京都市で屈指の内視鏡検査専門医
- みずもと内視鏡・消化器内科クリニックは、京都市伏見区深草で開業している、胃カメラや大腸カメラに代表される内視鏡検査専門クリニックになります。地域の内視鏡室を目指して、こだわり...
-
- 豊田市のこの内科院で治療しよう
- 豊田市の病院で最近で、はオンライン診療なども付加機能の一つとして考えることができますが症状や疾患に、マッチして適切な方法を選択することが肝要です。依頼先は調子管理や病気のホス...

-
- 仙台でマウスピース矯正に強いクリニック
- マウスピース矯正を仙台でするなら、どんな基準でクリニックを選ぶと良いでしょうか。腕が確かなことは大前提です。技術が高くないと、願うような結果が得られないからです。マウスピース...

-
- 大阪府枚方市でおすすめのいびき外来
- 規則正しいリズムの生活や禁煙や減塩や30分以上の有酸素運動や低糖質やベジファーストや腸活や低脂質や温活や筋トレや脳トレや菌活など、健康な体をキープするために取り入れたいこと・...

-
- 豊田市で予防接種を受けましょう!
- 病気に成ると我々の生活は一変してしまいます。まず病院に通院する必要や、入院を余儀なくされてしまうのです。すると仕事を休んだり、家事や育児にも専念できなくなってしまい生活がまま...
-
- 釧路の歯科選びはネットを活用しよう
- 措置費の不透明さがある病院は安心して施術を、依頼することができないため問題点として挙げられます。歯の困難は突然起こること、があるため事前契約が取りづらい釧路の歯医者は大変不便...

-
- 福島で最近話題の治療法とはなにか
- 睡眠時無呼吸症候群は睡眠中に一時的な呼吸停止が、起こる症状でありお口ツールを使用することで呼吸をスムーズにすることができます。、正確な装置の調整や指導を受け依頼者は睡眠時無呼...
-
- 船橋にある不妊治療をサポートする病院
- 船橋にあるこの不妊治療を行う病院では、20代から40代まで様々な年代に応じたプランを打ち出してもらえるのです。検査をしながら最適な計画を立て妊娠を実現するような取り組みを実施...

-
- 春日井市で内科を選ぶ時の注意点とは
- 批評は場所にとってさらなる措置の質の向上や相談者さんたちに、対するサービスの改善などに役立つ貴重なヒント源となります。施術者療処置の口コミに、は様々な種類が存在します。以下に...
-
- 平尾でマウスピース矯正したい人へ
- 福岡市内にはたくさんの歯医者がありますが、その中でも平尾駅近くで歯並びを治療したい人にご紹介したいのが友枝歯科・矯正歯科クリニック平尾です。このクリニックは平尾駅から徒歩圏内...

-
- 体調を崩した時はすぐに八幡西区の内科へ
- 年末年始になるとすごく忙しくなるので、どうしても体調を崩しがちになります。仕事や学業はもちろんですし、忘年会や新年会などの飲み会が重なることも多いです。美味しくてカロリーが高...
-
- インプラント生活を福島で充実させる
- 福島のインプラント治療で患者は最新の技術やアプリケーションに関心を持ちより先進的な医院を、選ぶ傾向があるのです。したがって相談先は常に最近の機能を取り入れること、で相談者の期...

-
- 小牧市の透析専門医に相談してから治療
- 愛知県の小牧クリニックは、透析専門医が治療を行っています。小牧市内で糖尿病や高血圧、高脂血症など生活習慣病の悩みを持っている場合は気軽に相談できます。小牧クリニックでは患者の...
-
- 医療用スクラブのオンラインショップ
- ユニフォームのチトセ公式オンラインショップは、飲食店や医療現場で働く方が着用しているユニフォームを販売しています。ファッションメーカーやスポーツメーカーとの共同開発商品、オリ...

-
- 新居浜にあるリハビリサービスについて
- 新居浜にあるこの会社はリハビリサービスを実施しており、時間制で対応してもらえるため、料金も明確になっているのです。また、介護保険料を適用した場合の価格表も対応しているため、リ...
-
- 今治市で歯医者をお探しならここへ
- 愛媛県今治市にある『ときわ歯科医院』は歯医者が苦手な方でも気楽に来院できるよう、明るく開放的な快適空間でリラックスして、また清潔安全に安心して受診しできる歯科クリニックを目指...

-
- 札幌エリアで注目のホワイトニング
- 札幌周辺に住んでいる方で、白い歯を目指したい方は必見です。まず第一印象をどうにかしたいのであれば、白い歯というのも一つあげられます。笑ったときにみえる歯が汚いと、印象は悪くな...
-
- 高津区で循環器の診察を受けるなら
- 健康診断を受けて数値が、医療機関での診察の必要ありと診断されてしまったと困っている人は多くいます。健康診断は日頃の生活習慣が検査結果にダイレクトに現れるもので、偏った食生活や...
-
- 戸田駅周辺で歯医者を探してみよう
- 戸田駅から徒歩10分のところにあるラビット歯科はとても人気があります。いろいろな治療ができるのですが、中でも無痛歯科治療を心がけているところが評判です。誰でも痛みのある治療は...

-
- 広島市南区の内科で脂質異常症を治療
- 広島市南区に位置するしまもと医院は、脂質異常症の治療において地域で信頼される医療機関です。第三者目線で見た場合、しまもと医院は専門的な内科医師とスタッフからなるチームによって...
.jpg)
-
- 小山市のインプラントも可能な矯正歯科
- 栃木県小山市の覚本歯科医院は、駅南町でインプラントと審美歯科、予防歯科を扱っている矯正歯科クリニックです。患者さんが毎日明るく過ごすために、35年以上の経験と実績がある院長を...

-
- 医療用ウィッグならアンベリール
- つむじのあたりからおろしていた重めの前髪を伸ばしてワンレングスにしたいけど伸ばしかけの状態がとにかく中途半端で見苦しい、グレーヘアで開き直る勇気が無く頻繁に染めて白髪を隠して...

-
- 可児市にオープンした眼科クリニック
- 岐阜県可児市の桜ケ丘安田眼科は、2023年3月に桜ケ丘にオープンした、比較的新しい眼科クリニックです。良質かつ高度な眼科医療を掲げ、身近に快適で安全な診療が受けられるクリニッ...

-
- 浦和の歯列矯正は歯医者選びが重要
- くろさき歯科でクレジットカードを、実施する場合は施術お金をクレジットカードで決済い分割払いやポイント還元などの特典を、依頼することができます。ローンを利用するケースは金融機関...

-
- 静岡市の歯医者で信頼できるところの特徴
- 静岡市の歯医者でそのため施術の進行に、伴って出費が変わる可能性があることを事前に説明してもらい措置に進む前に、再度算出を出してもらうことが重要です。予算を出してもらう際にはメ...

-
- インビザライン歯科選びの気を付ける点
- 昔に比べて矯正治療などが人気になっていますが、一体多くの人達はどういった時でこうした治療をすすめたいかと言う事になっているのでしょうか。確かにサラリーマンなどの未来なども増え...

-
- 豊島区で矯正をする人が増えている理由
- 同医院では修正を導入すること、で多くの依頼者に歯列改善治療を受けやすくなったとのことです。同クリニックの院長で、ある広川和馬先生によると「透明な口腔器具を使用するため療養中の...

-
- 葛飾区でおすすめの眼科をご紹介
- 今の時代はパソコンがないと何もできないくらい様々な場面で必用になることがあると思いますが、その影響でずっとブルーライトの光を目に浴び続けていることで、いつの間にか深刻な視力低...
-
- 徳島で利用しよう、病後ケアの専門事業
- 昨今は若い世代の間でも、大きな疾病を患って長期間の療養を必要となさる方が多くなりました。とくにガンの場合は胃や大腸などの臓器の一部を切除することになるため、約2年以上の自宅療...
-
- 京都で矯正治療ができる専門のクリニック
- 歯並びがよくないと食べ物をよく噛んで食事をすることが難しくなるほか、食事などの際に使用する歯が自然とかたよってしまい、頭痛や肩こりなどの全身的な症状に悩まされることがあります...
-
- 京都で信頼できる歯科矯正を受けよう
- 一言で矯正歯科といってもその中身は多岐に渡ります。現在歯科クリニックはコンビニより多いとも言われています。病院の診療科目は内科や外科、小児科等等様々な診療科目に分かれますが、...
-
- みなとみらい地区で内視鏡検査ができます
- 健康は誰にとっても大切なことであるため、いろいろな方法で健康の維持に取り組む必要があります。食事や睡眠が大切な要素になりますが、体調が悪くなったとしてもわかりにくい場合があり...

-
- 今治市にあるかかりつけに最適な歯科医院
- 歯を健康に保つことは全身状態にも良い影響があるとされています。ですが、歯の健康はセルフケアでは防ぐことが出来ない場合もあります。そのため、最近は定期的な検診とクリーニングが重...

-
- 宇都宮で矯正をするときの費用は?
- 宇都宮エリアに住んでいる方で、歯並びの事が気になっている方は必見です。まずこれは自分の努力ではどうにもならないですし、歯列矯正をしなければなりません。お子さんのかみ合わせが悪...

-
- 久我山井の頭通り・アクセス良好な眼科
- 「ほりかわ眼科 久我山井の頭通り」は、京王井の頭線「久我山駅」北口より徒歩7分のところにある眼科です。診療受付時間は、月〜水、金・土曜日の9:00〜12:30、月・火・金・土...

-
- 新宿のクリニックで生活習慣病を治そう
- 現代社会において、私たちはストレスや不規則な生活習慣、そして栄養不足などの問題に直面しています。このような生活習慣の乱れは様々な健康問題を引き起こす原因となっています。そのよ...

-
- 新宿で睡眠外来がある病院はどこ?
- 最近の日本社会はストレスの多い社会と言われているほど、仕事や学校、友人や親戚づきあい等で悩んでいる方が多くいました。それは2020年のコロナ禍によってさらに拍車がかかったとい...

-
- 浦添市の歯医者はどこも同じではない
- 例えば治具をしっかりと装着し指示された通りに清掃やケアを行うことが大切で、す。食事の際には硬い食べ物や粘着性のある食べ物を避けることでブラケットやワイヤーが、破損することを防...

-
- 奈良市で通院しやすい歯科クリニック
- たかだ歯科医院は奈良市富雄駅徒歩1分の場所に所在しており、むし歯治療や歯周病など一般歯科診療はもちろんのこと、かみ合わせの改善など歯の基本的な健康回復と維持を行ってきました。...

-
- 好待遇な介護士求人を募集する福祉会
- 阿倍野区で多数の老人ホームを運営するこの社会福祉法人では、介護士求人を行っており、10か所以上の施設を有しているので、配属先が多いことで求人を常に募っていることが現状です。介...

-
- PCR検査を白石区で受けたいときには
- 風邪などの諸症状が見られたり、発熱があったときには出来るだけ早期にPCR検査を受けるべきです。札幌市白石区では、「白石内科クリニック」でPCR検査を受けられます。クリニックは...

-
- 宇都宮でマウスピース矯正で歯並び改善
- 宇都宮にある「りょう矯正歯科クリニック」は、歯並びを改善する歯列矯正治療を専門に行っている歯医者さんです。院長は日本矯正歯科学会の認定医ですので、レベルの高い歯列矯正治療を受...

-
- 安心の歯科医院を鶴ヶ島市内で探すなら
- 鶴ヶ島市の歯医者で信頼できるところの特徴がわからず、もしもで不安等があれば、街中にある歯科それぞれの比較や検討に時間を設けるようにしておく事等がとても大切なポイントとなってく...

-
- 東京都北区赤羽の皮膚科で最適な治療を
- 日常生活を送っていると、意外と肌トラブルの多さに気づくことがあります。例えばストレスから来る暴飲暴食によって肌にダメージが蓄積していくこともあれば、汗をかいた後に顔をしっかり...

-
- 岡山市近くのエリアの近くでインプラント
- たんじフレンド歯科は、岡山市北区一宮で開業しているデンタルクリニックになります。「敷居は低く、窓口は広く」をモットーにしており、歯科領域にまつわる病気や症状の治療に積極的に取...

-
- 白井市で無痛分娩が今とても注目
- 無痛分娩に興味がある方は必見です。お産というと苦しくて痛くてつらいというイメージが強いかもしれません。そういった声が多いというのもありますし、二人目以降の場合は様子が分かって...
-
- 博多で質の高い矯正歯科を利用しよう
- 歯並びが悪いことにずっとコンプレックスを抱いている場合、自分の容姿に自信が持てなくなって人前で話すこと自体苦手になってしまうことも十分に考えられるので注意が必要です。あまりに...
-
- 札幌市西区でも胃カメラ検査ができる
- 歳をとってくると様々な病気になるリスクが高くなります。医療が進歩したことによりガンになっても助かる可能性が高くなりましたが、ステージが進んでしまうと助からないことがあるため、...

-
- 落合南長崎で矯正を依頼するに最適な歯科
- 最近は歯科医院がまとめられているサイトなども、かなり充実してくるようになっていると言う事が言えるようになっています。とにかく最近は、コンビニよりも歯科医院の顔そう言うような事...

-
- 要町の矯正歯科で矯正するならば
- 最近はインビザラインなどの見えない矯正治療などが多くの人達に人気になってきている傾向もありますが、どこに依頼すれば良いかがなかなかわからないと言うことで悩む人なども多くなって...

-
- 総合診療ができる堺市の歯科医院
- この医療機関は、堺市にある歯科医院です。一般診療に加えて高度な自由診療も取り扱っており、外科手術室を備えて専門的な治療を行う環境が整っています。その一方で、小児歯科や定期健診...

-
- 胃カメラをするのに便利な練馬区の病院
- 練馬区で診療をしている「金田医院」では、経鼻内視鏡で胃の検査をすることができます。胃や食道などの病気が疑われる時には胃カメラでの検査を行いますが、今までに他の病院で口から入れ...
-
- 八幡西区で信頼できる小児科を探そう
- 子どもの体調はコロコロと変化することもあり、健康管理でお悩みの親御さんも多いのではないでしょうか。元気にしていたと思っていても、急に熱を出すなど体調の変化も起こりやすいので日...
-
- 札幌市西区ですぐにPCR検査を受けたい
- いまコロナの感染者数が爆発的に増えている状況ですし、発熱してしまって外来を受診したいと思っても混雑していて電話も繋がらないという声もおおくよせられています。発熱の場合はそのま...
-
- 北九州市の心療内科についてのいろいろ
- 心療内科と言えば、心の病を診たり治したりする診療科のことであり、聞き慣れない人もいるかもしれません。わかりやすく言うならば、精神科の範疇ですから、精神的なものを治療する科と理...

-
- 安佐南区で精密治療を受ける前の注意点
- 歯医者の数がかなり多くなってきており、安佐南区でコンビニよりも多いと言うような状況が生じています。実際のところ全国フランチャイズ協会などのデータでは、コンビニは家庭5万程度と...
-
- ホームホワイトニングが受けられる歯医者
- 守山区にある「ききょう歯科クリニック」は、一般歯科治療の他に審美歯科治療も行っている歯医者さんです。一般歯科治療は虫歯や歯周病など、歯や口腔内の疾患を治すために行う治療です。...

-
- 目黒区からも立ち寄りやすい小児歯科
- 三軒茶屋矯正歯科クリニックは、東京の目黒区からも立ち寄りやすいクリニックです。子供の歯列が乱れている場合は、小児矯正で治療を受けられます。顎骨が柔らかい時期に始める矯正治療は...

-
- 本八幡の眼科の医者選びは最初が肝心
- 以前よりも目の治療の人気がかなり高くなっているというのは、本八幡でどこの眼科医院でも見られる傾向ですなので、何よりも目の治療と言うと小学生などの子供が依頼するというケースがほ...

-
- 石神井台にある地域に根差した内科医院
- 練馬区石神井台にある「金田医院」は、地域のひとりひとりが自分らしい生活を送れるよう医療サポートをしてくれる地域に根差した内科医院です。院長は日本大学医学部を卒業後、日本大学第...

-
- 札幌で満足度の高い治療を提供しています
- オールオン4とは、総入れ歯の方をはじめ多くの歯を失っている方向けのインプラント治療のことで、従来の方法とは異なり少ない治療回数や手術当日には仮歯が装着できるのが最大の特徴です...
-
- 毎月1度山形の病院から泌尿器講座の発信
- 株式会社山形コミュニティ新聞社は、地域密着型のフリーペーパー「やまコミ(yamacomi)」の制作会社です。地域社会およびそこで暮らす人々をコミュニティと呼びますが、コミュニ...

-
- 松山市でホワイトニング施術を受けるなら
- 松山市にあるこちらの歯科クリニックは様々な診療科目を取り扱っており、くすんだ歯を白く戻すホワイトニング施術も提供しています。歯に黄ばみがあるため悩んでいる、もとの白い歯に戻し...

-
- 肌が荒れているなら北参道皮膚科へ
- 今はマスクの着用が定番化してきていることもあり、毎日使用していることで肌荒れを引き起こしている方が増えてきています。その主な原因としては、汗を掻いたまま放置してしまうことで肌...

-
- 市川市内で白内障治療で眼科を探すなら
- 目の病気で年齢を重ねると、罹患者が増えると言われているのが白内障です。50代の約5割が視力の低下や目のかすみや、光を異常に眩しく感じるといった症状を感じる病気です。目の中にあ...

-
- 東長崎で評判の矯正クリニックについて
- 歯は生きている限り、一生付き合っていかなければいけません。歯が健康で丈夫で維持できていないと、食事をおいしく食べることができないからです。食べることは生命維持に欠かせません。...
-
- 梅田にある精神科で確実な改善をする
- 梅田にある精神科クリニックは、カウンセリングを特に重視しており、そのカウンセリングをもとに治療のターゲットとすべきポイントを的確にとらえて患者の目線に立った治療を行っています...

-
- 岐阜市で高血圧症の治療を行うなら
- 健康を維持するためには、自分の体の状態を把握することも大事です。健康診断では様々な検査が行われますが、血圧の高さを指摘された経験を持つ人も多いのではないでしょうか。血圧が少し...
-
- 松山市で歯科医院選びの気を付ける点
- 今は歯科医院で治療しなければいけないものがあるけれども、松山市でなかなか治療が進められないということで悩んでしまうということになっていることはご存知でしょうか。多くの人がその...

-
- 松山市にあるマウスピース矯正の紹介
- 松山市にあるこのクリニックでは、マウスピース矯正を取り扱っています。顎の状態やかみ合わせをチェックしたうえで、確実に効果のある患者を見極めて対応してもらえるので安心です。マウ...

-
- 栄でマウスピース矯正治療を選ぶ事が可能
- 虫歯や歯周病などは放置することで悪化してしまうので、直ぐに適切な治療を受ける事が大切です。口内トラブルとして虫歯だけでなく、歯並びの改善なども重要な治療方法となります。歯並び...

-
- 堺市でインプラント治療を受けるなら
- 堺市にある医療法人田中歯科医院は、歯科治療は痛い・怖いというイメージや認識を変えてくれる歯医者さんです。歯科疾患で大切なのは予防と早期治療ですが、怖い・痛いというイメージがあ...
-
- 松山市で矯正治療をする前の注意点
- お子様で歯並びなどに問題があるような時には、松山市でどのような方法でしっかりと始めるべきなのかということが悩んでしまうことも多いかもしれません。受験やスポーツの大会などは控え...
-
- 大阪で整形外科の治療を受けたいなら
- 大阪には、いくつかの治療院が存在しますが、整形外科などはそこまで多いわけではありません。整形外科を受ける理由にもいろいろなものがありますが、美容整形と少し異なり審美を求めるも...
-
- おすすめの豊田市の内科について
- 豊田市にあるこの内科は病気だけでなく生活習慣の改善にも努めています。いろいろな検査を通じて、生活習慣の改善状況を把握して、数値で患者のモチベーションを上げていったくれるのです...

-
- 赤羽の皮膚科でアレルギーの治療をする
- 赤羽には皮膚科がたくさんあります。その中でももし通院するとしたらどこに通うべきでしょうか。それは自分の皮膚の疾患によって選択をすればいいでしょう。たとえば、一般の皮膚疾患を対...
-
- 見えない矯正治療に特化したクリニック
- 綺麗な歯並びにあこがれている人は非常に多いです。アメリカやヨーロッパの人は、みなきれいに歯が並び白い歯を思いっ切り見せて笑顔になり、非常に魅力的に見えるものです。こうした西欧...

-
- 釧路ではインプラントは保険はきくのか
- 最近はインプラント治療を受けたいと考える人が、釧路で多くなってきている傾向がありますのであなたも良くないはこの治療法をチェックしたことがあるのではないでしょうか。これは人体に...
-
- 北九州市で評判の精神科について
- 精神科はうつ病や依存症、統合失調症や睡眠障害の他に摂食障害や適応障害など精神疾患を治療する診療科です。似たような診療科に心療内科がありますが、精神疾患ではなく心理的な要因で身...

-
- 久米川で安心できる歯科医を見つけよう
- 最近はこの町にもかなり歯医者さんの数が増えてきた、というような印象を久米川で持つことはないでしょうか。実際のところその数は、全国に7万から8万近くあるとも言われコンビニの数も...

-
- 豊島区で選ばれている歯科クリニック
- 豊島区エリアにお住まいの方で、歯並びの事を相談したいという事であれば対応しているクリニックを探すことからスタートです。まず一般歯科のみで書かれている所は、虫歯や予防歯科や歯周...

-
- 椎名町の歯科クリニックについて
- 歯科は歯や口の中の病気を専門的に診るところです。特にむし歯などはよく知られています。高度な技術を必要とするインプラント、矯正歯科、審美歯科もあります。より高度な臨床的な分野で...

-
- 広い待合室が存在する板橋の医療施設
- たくさんの患者が通院している板橋区の医療施設なのですが広い待合室が存在しており、のんびりと順番が来るまで待てる環境が整えられています。静かで落ち着いた雰囲気も保たれており、観...

-
- 近くで予防歯科診療を受けるなら
- 糖尿病や高尿酸血症や高脂血症や高血圧症や脂肪肝やメタボリック症候群など、40歳を過ぎると発症リスクや重症化リスクが高くなる生活習慣病には様々なものがありますが、最も怖いのが動...
-
- 近くでインプラント治療を受けるならここ
- インプラント治療とは、人工歯根を顎の骨に埋め込んで、その上に人工歯をかぶせる治療です。口の中の違和感をほとんど感じないため、特にお年寄りに人気があります。入院の必要性がなく、...
-
- 専門医が大腸検査をする横浜のクリニック
- 粉川敦史氏が院長を務める粉川クリニックは、横浜市中区にあります。最寄り駅はみなとみらい線の通る馬車道駅で、歩いて1分の距離です。市営地下鉄の関内駅からも徒歩3分ほどです。市営...
-
- 高津にある内科の紹介になります
- 高津にある国島医院は、内科・循環器科を掲げている医院になり、高津区のホームドクターとして地域医療に貢献しています。一般内科や生活習慣病などの診療を主におこなっている医院です。...

-
- 目黒区において長期的に歯科に通う時は
- 歯医者に通うことが少し大変に感じたり、目黒区において億劫に感じるというような事がありませんか。治療しなければいけないことはわかっていても、そのせいでなかなか通えないというよう...
-
- そけいヘルニアの症状と治療方法
- 「足の付け根に膨らみがある」「横になったり、押さえたりしたら引っ込む」「下腹部に違和感や不快感がある」、こうした症状は「そけいヘルニア」の可能性があります。「そけい」とは足の...
-
- 安全で綺麗なセラミックならこの歯医者
- セラミックでは、見た目の美しさである審美性はもちろんですが機能性も兼ね備えている必要があります。実際に、品質が悪いものを利用すると割れやすくなってしまったり他の健康的な歯の邪...
-
- 秋葉原の歯医者は原田歯科クリニック
- 原田歯科クリニックは秋葉原駅から徒歩1分、駅から近く通いやすい歯医者です。温かみのある木材とシックな色合いを取り入れた院内は、落ち着きのある洗練された空間となっています。歯科...

-
- 郡山市で一押しの歯科クリニック
- 郡山市エリアにも歯医者さんは多数あります。歯は自然治癒することが出来ませんので、かかりつけ歯医者さんが有ると安心です。定期的に予防歯科で受診をしていれば虫歯になるリスクも少な...

-
- 品川から近い芝浦のレディースクリニック
- こちらは、品川駅からもアクセスの良い芝浦にあるレディースクリニックです。産科と婦人科を診療していて、女性の病気や出産に関することを広く診ています。中絶手術も扱っているので、中...

-
- 髭剃りもスムーズになるイボ治療
- 年齢を重ねることが原因になることと、ウィルスが引き金となるケースがあるのが皮膚に生じるイボ、できてしまっても諦めることなく、東京のクリニックでのイボ治療が良い改善方法です。積...

-
- 島田市で安心して利用できる眼科
- 若いときは視力がよかった人でも、歳を重ねることで徐々に視力が落ちてしまうことがあります。視力が落ちることで視界がぼやけるなどの弊害がありますが、余りにも視力が悪いと普通に歩く...
-
- 住吉区にあるおすすめの介護老人保健施設
- 住吉区で介護老人保健施設の利用を検討しているという方は、社会福祉法人帝塚山福祉会が運営する介護老人保健施設聖和苑がおすすめです。清潔感のある4階建ての建物となっており、入所サ...

-
- 優しくわかりやすく丁寧な伊丹市の歯科
- 伊丹市にあるこの歯科は、外観は白と紺色を基調とした爽やかなデザインで、ハチドリのマークと時計が目印です。内部も清潔な空間を演出していて、受付や待合室の床は木材を感じさせるデザ...
-
- 天神でホワイトニングをやってみよう
- 自分の顔を鏡で見たときに残念だなと思ったことはありませんか。顔のパーツの中でも歯というのは結構なスペースを占めるものです。口の状態が汚いと相手に悪印象を与えてしまうことでしょ...

-
- 宇都宮市でおすすめの矯正専門歯科
- こちらは栃木県宇都宮市ゆいの杜でクリニックを構える、「りょう矯正歯科クリニック」が運営するウエブサイトになります。2015年10月に開院して以来、矯正専門歯科として歯列矯正治...

-
- 岐阜市で高血圧症の治療を行うなら
- 健康に不安を感じる人は、まずは健康診断を受けて現在の自分の体の状態をしっかりと把握しておくことが大切です。健康診断ではレントゲンや心電図、さらに血液検査など様々な検査が行われ...

-
- 堺市泉北でインプラント治療を受けたい
- インプラントとはチタンなどを使い、歯の根を根本的に治療するものです。堺市泉北に近い「田中歯科」では、ISOI国際口腔インプラント学会に所属している医師が在籍する歯科医院で、さ...

-
- 秦野市の地域の人々のための歯医者
- 乳歯が生えてから永久歯に生え変わる、中学生くらいまでの年齢の中での歯科治療を行うのが小児歯科といわれています。乳歯の段階で歯の健康を維持することは大人になってからも虫歯になり...
-
- 今治市で人インプラントを受けるポイント
- 歯を失ってしまった治療と言うと、以前は入れ歯や差し歯、それからブリッジなどといった方法が主流でしたが、最近インプラントという方法も登場し、多くの人達から注目を集めるようになっ...
-
- 岡山市北区で信頼できる歯科医を見つける
- 歯の治療はしなければいけないと思いつつも、なかなか通う勇気が出ないと言ったことでお悩みではないでしょうか。しかしそうしたことは別に勇気の問題ではなくて、かつて岡山市北区であま...
-
- 仙台でうつ病の治療はマドレクリニックで
- 鬱病は誰でも起こりえる病気です。うつ病になるのは心の弱い人だという偏見は過去にありましたが、今は決してそのようなことはなく、脳の異常による病気であることが立証されていますので...

-
- 札幌市で胃内視鏡検査を受ける前に
- 胃内視鏡や大腸内視鏡検査を受ける前に、確認して欲しいことがあります。内視鏡検査を受けようと思っているクリニックがすでに決まっている場合は、そのクリニックに日本消化器内視鏡学会...
-
- 仙台のクリニックで見えない矯正を実施
- 仙台では見えない矯正を実施しています。自分の歯並びが気になる方は多いものです。接客業など、日頃から人前に出る機会が多い方は、歯並びの良さを気にするからです。仙台の歯科医では、...

-
- 海老名で歯の健康を真剣に考える歯医者
- 虫歯や歯周病は、日頃からの予防がとても大切です。症状が現れてから歯医者に行き治療をするという方も少なくありませんが、そのような状況になる前に予防に力を入れて、健康な歯を守る意...

-
- 担当医と信頼関係が築ける阿倍野区の歯科
- 医療法人A&D文の里歯科クリニックは、大阪市阿倍野区の地下鉄谷町線・文の里駅を含めた複数路線で通うことができる便利の良い歯医者さんで、終日無料の専用駐車場もあるので、車での通...
-
- 矯正の値段が安く定評があるクリニック
- 綺麗な歯並びになりたいと思っている人は日本では非常に多いのではないでしょうか。日本人は欧米人に比べると顎が小さい人が多く、いびつな歯並びになっている人が珍しくありません。さら...

-
- 土曜日もやっているひたちなか市の眼科
- 中村丹雄氏が院長を務める中村眼科医院は、ひたちなか市にあります。最寄り駅はJR常磐線と茨城交通湊線の通る勝田駅で、東口から歩いて3分の距離です。38台が停められる専用の駐車場...
-
- 豊富な種類を取り揃える飛沫感染パネル
- パーテーションは、感染予防対策グッズとしてさまざまな場所で使われています。飲食店ではテーブルやカウンターの上に設置し飛沫が飛ばないように対策をしたり、受付などでも飛沫感染パネ...
-
- 大阪の内視鏡検査に対応するクリニック
- 大阪府堺市には胃や大腸の検査ができる医潤会内視鏡クリニックが所在します。胃や大腸内の専門のクリニックで、経験豊富な医師が常駐しています。堺東駅・堺市駅から徒歩8分のところに位...
-
- 名古屋で最新式の大腸カメラを備える所
- 名古屋市天白区にある「ばんのクリニック」では、日本でまだ数件の医療機関でしか導入されていない最新式の大腸カメラを備えている医療機関です。2016年に開業して以来、年間約500...
-
- アトピーの治療を行える港北区の病院
- この港北区の一般皮膚科はアトピー性皮膚辺の治療も得意としています。アトピー性皮膚炎は角質層などで、外的な刺激などに対して起こるアレルギー反応が原因です。慢性的にかゆみや炎症を...
-
- 神戸市の内科で内視鏡検査を受けたい
- 飲酒や喫煙の習慣があったり、ストレスの多い生活をしている人は、腹部の痛みや胸やけ、下痢や軟便などで悩んでいる人が少なくありません。胃潰瘍や十二指腸潰瘍、大腸ポリープ、大腸がん...
-
- 厚労省認定の金沢市の歯医者さん
- 金沢市の歯科医院あおば歯科クリニックは、厚労省認定の」かかりつけ歯科医機能強化型歯科診療所」として地域住民の健康をサポートしています。この制度は歯科疾患の重症化予防や高齢者の...

-
- 審美ブラケットでの治療が受けられる
- 宇都宮にある「りょう矯正歯科クリニック」は、歯並びを良くする歯列矯正治療を専門に行っている歯医者さんです。宇都宮エリアには歯列矯正治療を行う歯医者さんも少なくありません。ただ...

-
- 豊田市の頼れる内科で不調を治す
- 身体の不調を感じたときに、頼りになるのがかかりつけ医の存在です。豊田市にある「井上医院」は、地域の人々の身体の不調に対して真面目に取り組んでくれる病院です。内科・小児科・皮膚...

-
- 永福町のおすすめアレルギー科です
- 永福町駅から徒歩3分の立地にある、永福町駅前みんなのクリニックは様々な受診科目があります。内科や消化器系や泌尿器系、外科や小児科や小児外科、またアレルギー科にも対応しています...

-
- 田町近くで避妊の相談が出来る婦人科は?
- 女性にとって「避妊」は大切な問題です。男性側でよく知られている避妊法はコンドームですが、女性の側ではあまり話題にされないことかもしれません。田町駅の近くに、みなとウィメンズク...

-
- 横須賀市で歯科医院を受診するなら
- 長嶋デンタルクリニックは1996年に横須賀市大滝町で開業して以来、地域に密着した治療を行ってきました。電車では京急本線の横須賀中央駅で下車し東口より徒歩5分、京急本線の汐入駅...
-
- 千代田区で内科をお探しの方に最適
- 体調が優れないとお感じの方、健康相談をしたい方など、日常的な身体に関することを診察してもらうことができるのが「内科」です。風邪のような症状で病院に行くといった場合に第一に選択...
-
- 宮崎市で歯並びを綺麗にしませんか
- 歯並びがあまり良くないのならば、放置しない方が良いです。特に問題がないから、このままで良いと思ってしまうかもしれません。歯医者が苦手な人が多いですし、痛みがないなら行かなくて...

-
- 横須賀中央で実績多数のインプラント治療
- 京浜急行横須賀中央駅の周辺エリアでインプラントを考えているなら、長島デンタルクリニックがおすすめです。長島デンタルクリニックは横須賀中央で10年間もインプラント治療を行ってお...

-
- 荒川区でかかりつけ医として活躍する内科
- 医療法人社団久悠眞会 山本医院は、荒川区のかかりつけ医として長年信頼され続けてきた医療機関です。昭和32年に開院してから70年近い歴史があり、4代に渡ってかかりつけ医として治...

-
- 赤羽で幅広い治療メニューが受けられる
- 皮フ科イガラシ医院は、東京都北区赤羽駅からすぐのところで皮膚科診療を行っている医療機関です。こちらではあらゆる皮膚のトラブルを解決できるよう、一般的な治療に加え、自由診療を含...

-
- 静岡でも話題の眼内コンタクトレンズ治療
- 眼内コンタクトレンズ治療は静岡でも話題で、島田市の金谷眼科で治療を受けられます。ホールICLと呼ばれる眼内コンタクトレンズ治療は、角膜を削らない視力回復方法です。見え方が鮮や...
-
- 阿倍野区でインプラント治療が増えている
- 阿倍野区でインプラント治療を受ける方が増えています。店舗での接客業などに従事する方は、人並み以上に口元を気にするものです。綺麗な歯並びを維持することにより、相手に好印象を抱い...

-
- アンベリールの医療用かつらの試着
- 医療用かつらやウィッグの通販やレンタルを行なっているアンベリールは、高品質でありながらリーズナブルというコストパフォーマンスの高さが人気となっています。自然でありナチュラルで...

-
- 奈良でレディースクリニックをお探しの方へ
- 奈良県奈良市にある「洋子レディースクリニック」は、婦人科や産科などを診療科目とする病院です。近鉄奈良線の学園前から近いため交通アクセスに優れ、専用の駐車場も完備されています。...

-
- 全ての患者に寄り添う神奈川の矯正歯科
- この矯正歯科は神奈川県で開業している、歯の矯正においてはプロフェッショナルな仕事を通じて、全ての患者さんに満足してもらっている優れた歯科です。利用に際しては、公式サイトから電...

-
- 石神井で通いやすい消化器内科です
- 石神井周辺で、胃腸の調子が悪くて良いドクターを探している方にお勧めなのが金田医院です。金田医院は、消化器内視鏡専門医のドクターが丁寧な診療を行っており、武蔵関より徒歩9分とア...
-
- 歯を大切に扱う松山市の矯正歯科
- 松山市和泉南の大谷歯科は、歯を大切にする治療を心がけているので歯並びの改善を考えている人に最適の矯正歯科です。不必要な治療を無理に強要するような事は無く、一人一人の歯の状態を...

-
- 清潔な西宮市のクリニックでインプラント
- 明るくて清潔な西宮市のアルティス歯科・口腔外科総合クリニック西宮北口は、インプラントやホワイトニング・矯正など診療科目が多いので知っていると便利です。知識豊富な専門医が患者の...
-
- 不妊治療に喫煙はひかえましょう
- 結婚し家族計画を立て、子供がどうしても欲しいのになかなか授からないカップルが多くなっています。それは遺伝的なもの、体質的なものと諦めている人も少なくないでしょう。しかし不妊の...

-
- 地域と連携の取れる老人ホームの魅力
- 群馬にあるこの有料老人ホームでは、地域に根ざした観点からサービスを提供している魅力があります。利用者が安心して過ごせる環境を提供していますので、安心して任せられます。一般的に...

-
- オンライン診療が足立区で受けられます
- 時間や費用を節約することができるオンライン診療は、感染症にかかるリスクを低減することができることもあって、世界的に注目を集めています。移動にかかる時間や費用をなくすことができ...
-
- 自分の歯を残すことに力を入れている
- 医療法人尚志会林歯科医院は、自分の歯を残すことに力を注いでいる三重県松阪市の歯医者さんです。歯を失う原因は様々ですが、特に年齢を重ねた人に多いのが歯周病によるものです。歯周病...
-
- 川崎市で糖尿病の検査ができる病院
- 食生活の欧米化や飽食の時代といわれる現在糖尿病患者は年々増えていて、今では予備軍を合わせると2000万人程度いるのではないかといわれているぐらい、大きな問題となる国民病ともな...

-
- 一般歯科から自由診療まで幅広く対応
- 医療法人社団ヒロ歯科・口腔外科クリニックは、旭川市の宗谷本線・永山駅から徒歩圏内のところで開院している歯医者さんです。こちらの診療科目は一般歯科・口腔外科・様々な自由診療とな...
-
- 特定健診をしている岐阜市のクリニック
- 長良内科クリニックは岐阜市八代にあります。長良川の北にあり、周囲は住宅が建ち並んでいます。国道256号線に近く、停めやすい駐車場もあるため自家用車でアクセスしやすいことが魅力...
-
- 福岡市で噛み合わせ治療を気軽に相談可能
- 矯正歯科imamuraは、福岡市で噛み合わせ治療を考えている人が気軽に足を運びやすくなるよう工夫しているから、地域の人たちをはじめ矯正に興味がある人達が相談に訪れています。初...

-
- 医療かつらの試着が自宅で試せる
- 株式会社セラヴィの医療用ウィッグ・かつらの通販やレンタルのブランドであるアンベリールでは、医療かつらが自宅でゆっくり探せるメリットがあります。申し込みからの流れですが、まずア...
-
- 長い歴史と最新の技術を誇る歯科医院
- この医療機関は、最寄駅から徒歩3分という便利な場所にある山形市の歯科医院です。駐車場も10台分完備しています。予約制で診療を行っており、電話で予約を行うことができます。ウェブ...

-
- 疾患や矯正の治療を受けられる眼科
- 新宿にある医療法人先進会 先進会眼科 東京は、自分が受けたい眼科治療をテーマにしています。0120-049-113...

-
- 臨床研修施設に指定されている芦屋の歯科
- 兵庫県芦屋市船戸町にあるこの歯科医院では、無痛診療にこだわって患者の治療にあたっています。歯科での治療が敬遠される大きな理由の一つに、歯を削るときや神経を抜くときに生じる痛み...
-
- 旭川市で産婦人科を探しているのなら
- 産婦人科にかかるのであれば、女性に優しい病院にかかりたいと思うものです。北海道旭川市にある「みずうち産婦人科」は、60年以上も地域の女性の力となってきた病院で、現在では体外受...

-
- 港区で精神をケアしている心療内科
- この医療機関は港区で営業している心療内科です。さまざまな点で患者に思いやりを持って対応しています。仕事や子育て、学業など現代人を疲弊させる要素は、日常生活に溢れかえっているの...
-
- 東京都練馬区にある眼科クリニック
- 東京都練馬区の東大泉に2017年1月15日に開院した「医療法人社団恵香会やまぐち眼科クリニック」という、地元に密着したクリニックがあります。西武池袋線の大泉学園駅北口から徒歩...
-
- 京田辺市で胃カメラを任せられる
- こちらの診療所は、安心して京田辺市で胃カメラを受けることができます。胃カメラというと苦痛が伴うことから、とても敬遠してしまうことが多いです。このような評判が喧伝されていること...
-
- 宇都宮で歯列矯正するならこのクリニック
- 村山矯正歯科医院は、栃木県宇都宮市にあるクリニックです。歯列矯正を専門にしているクリニックで、最寄り駅から近いので通院しやすい環境です。歯並びの矯正にはある程度の時間がかかる...

-
- 腹部の問題も詳しく検査する大井町の内科
- お腹の調子が悪くて下痢を繰り返してしまう時には、食中毒が原因で下痢が続いていると思い込まずに、大井町の内科でCT検査なども含めて詳しい検査を行う事を推奨します。はやしクリニッ...

-
- 最新の設備が整った武蔵小金井の歯医者
- こいそ歯科クリニックは、武蔵小金井の歯医者で高度先進機器を完備し保険適用医療を中心とした治療が受けられます。土曜日も診療しており、ネット予約は24時間対応なので平日忙しい学生...
-
- 枚方市の内科は通いやすいです
- 枚方市の内科クリニックは、主要な駅から利便性の高い立地にあるので、忙しい人も通院がしやすいです。受付をしてから診察までの、待ち時間が短いので体調が優れない人も安心出来ます。現...

-
- セラミックなどを詰める歯のインレー再生
- 虫歯になった場合に、そのまま放置しておくと悪化していくので、歯医者に行くことになります。その処置の際には虫歯のある部位を削ることになり、その削った部位には型を取った銀を埋め込...
-
- 安心して透析を受けられる病院です
- 人工透析を受けなければいけない患者にとっては、そのための通院自身が苦痛に感じられてしまうことも少なくありません。長時間ベッドの上で拘束され、痛みを伴う治療を受けなければならな...

-
- 高度な生殖医療も可能な秋田のクリニック
- あきたレディースクリニック安田は、医療法人ALCYが運営を行っている女性専門のクリニックで、産科・婦人科・生殖医療・不妊治療などの産婦人科全般の診療を行っています。妊婦健診や...

-
- すきっ歯治療で用意された2通りの選択肢
- 表参道デンタルクリニックは、虫歯や歯周病の治療ではなく、口元をきれいに見せるための審美面を中心に行う歯科です。メニューの種類はホワイトニングやインプラントなど豊富で、虫歯治療...
-
- 郡山市の矯正歯科を提供する歯科医院
- 福島県にある南山歯科医院は、郡山市安積町の歯科医院で、ホワイトニングやレーザー治療と併せて矯正歯科を併設しています。口腔外科や小児歯科も含まれているので、対応力の高さは本物で...

-
- 三軒茶屋周辺で成人矯正をしたいなら
- 世田谷周辺で成人矯正を考えているのであれば、三軒茶屋矯正歯科クリニックに相談するのがいいでしょう。矯正と聞くと子どもが行うイメージが強いですが、健康な歯や歯根があれば何歳にな...

-
- 徳島の作業療法士によるデイサービス
- デイサービスを徳島で探しているのなら、作業療法士が運営するリハビリテーションに特化したサービスを提供する「For Youグループ」がおすすめです。国府と沖浜の2ヶ所にデイサー...

-
- 甲状腺の専門医を探しているのなら
- 甲状腺に関する悩みや相談ができる専門の医療機関を探しているのなら、「虎ノ門小澤クリニック」の受診をおすすめします。内分泌と代謝疾患を中心とした内科診療を、各学会の専門医がおこ...

-
- 無痛分娩なら鎌ヶ谷バースクリニック
- 女性にとって自分の身体の中に命が芽生えるという事はとても嬉しい事ではありますが、それと同時に男性にはわからない大きな不安を抱える事になります。命をこの世に送り出す出産というの...
-
- 金沢市で緑内障眼科を探しているなら
- 飛蚊症やドライアイや結膜炎や角膜炎や白内障や網膜症やぶどう膜炎など目の疾患には様々なものがありますが、緑内障もその一つです。緑内障は、眼圧が上がり視神経に異常が起こることで視...
-
- 富山でインプラント治療を受けるなら
- 隣接している健康な歯に大きな負担がかかってしまう、ちょっとした違和感が気になり食べ物を思いっきり噛むことが出来ない、食事や歯磨きの際につけたり外したりするのが面倒でお手入れの...

-
- 伊勢市にある信頼と実績の厚い歯医者
- 伊勢市で安心して治療を受けられる歯医者を探しているのなら、なかの歯科をおすすめします。信頼のおける学会認定医が在籍し豊富な実績を誇る等、安心と安全、確かな技術力で治療に取り組...

-
- 胃カメラ検査で病気の早期発見を
- 胃カメラ(内視鏡)の検査を行う場合は、おもに胃や腸などの消化器官系に関する病気の早期発見および早期治療のためとなります。内視鏡検査では、先端に高精細な画像を撮影できるCCDカ...
-
- 歯科矯正に定評のある京都の歯医者さん
- 前歯の歯並びが悪くて笑顔を見せることに抵抗感がある、噛み合わせの悪さと体の歪みとの関係性が気になる、歯が複雑な生え方なのでオーラルケアが難しくすぐに歯石や歯垢が溜まってしまう...

-
- 流山市に新しく開院した整形外科です
- はた整形外科は、流山市中央部を走る東武野田線と首都圏新都市鉄道の接続駅「流山おおたかの森駅」から徒歩で約10分の好立地にある整形外科ですが、すぐ目の前に患者専用の駐車スペース...
-
- 油断せずしっかり治すことが大切
- 主に足の指に起きる現象となる爪の白濁ですが、それは爪水虫の可能性があります。自覚症状がないことからそのままにしておく人も多いのですが、その油断が問題になることもありますので気...
-
- レーザー脱毛を行う日本橋のクリニック
- このクリニックは、東京中央区の日本橋でレーザー脱毛と一緒にお肌のケアも行ってくれる美容外科です。アメリカのキャンデラ社製の医療用レーザーを使用しています。これは医療用として開...
-
- 郡山の歯科が提供しているインプラント
- 福島県郡山市の「うすい歯科医院」は、13年の歴史を積み重ねてきた歯科クリニックです。良質な歯科治療を提供しているということから日本の歯科100選に掲載されており、院長はアジア...
-
- 産後ケアに力を入れる笠松産婦人科
- 今少子化が進んでいる日本では、お産を取り扱う施設も産科医の数も減少しています。かつては様々な条件から自分に合った産院を選ぶこともできましたが、現在は1時間以内程度で通える近隣...
-
- 宝塚で受けられるインプラント治療
- 歯を失ったときにはインプラント治療をすると、自然な外見で元のような機能を取り戻せます。宝塚ライフ歯科・矯正歯科でもこの治療を扱っているので、近郊の人は検討してみましょう。歯科...
-
- 熊本市で小児の歯列矯正が受けられます
- 熊本市にお住まいの方で、お子さんの歯並びが気になる時には経験と実績があるひがし歯科医院がおすすめです。経験と実績がありますし、審美歯科の治療に力を入れているので審美的な治療を...

-
- 胃の調子が悪いなら早めに検査を
- 多くの人が胃の調子が悪いと感じているのかもしれません。なんとなく調子が良くないけれど、すぐに良くなるだろうと思って放置していませんか。なかなか胃の調子が良くならないけれど、市...
-
- 有田市で最新の矯正治療を希望するなら
- 歯並びや噛み合わせの悪さで悩む人は多いですが、矯正治療を受けることでその悩みも解消することができます。とはいえ、矯正は長い期間が必要ですし、装置が目立つことに抵抗があるという...
-
- スタッフが全員女性で安心な婦人科です
- 婦人科というと敷居が高いと感じている女性は多いと思います。妊娠以外で訪れることに少々抵抗感があるのは、内診のイメージが強いせいかもしれません。しかし女性にとって婦人科はもっと...

-
- 気軽に胃カメラ検査を行いたい時に便利
- みぞおちのあたりに違和感を覚えているけれど、胃の検査は長い時間が必要なので検査を受けるのが面倒だと感じる人でも、やまうち内科クリニックなら胃カメラ検査を気軽に受けられます。豊...
-
- 豊富なメニューで対応してくれる歯医者
- こちらは東京池袋駅より歩いて5分の、グランドメゾンデンタルクリニックです。平日に加えて土日も診療しており、月・水・金は夜9時まで診療してくれます。平日時間が取れない人には助か...

-
- メタルフリー治療を受けられる歯医者
- 大分県の中津市にある「加来歯科」はインプラントをはじめとする、自費診療分野の治療を基本としている歯医者さんです。自費診療分野の治療には色々な種類がありますが、加来歯科ではメタ...
-
- 沼津で評判の高い審美歯科を選ぶなら
- 歯科医院は全国に実に多く存在しますが、それぞれ得意としている分野は違いがありますので、自分が望む治療が受けられるかはよく確かめておきましょう。最近は虫歯や歯周病の治療だけでは...
-
- 京都市で子供の歯列矯正をするなら
- 京都で子供の歯列矯正をするなら歯列矯正の専門医院である、「あおい矯正歯科」が利用できます。歯並びをなおすなら、やはり専門歯科でと考える人は少なくないようで、30年も専門歯科と...

-
- 会話や清潔を重視する矯正歯科クリニック
- 三軒茶屋矯正歯科クリニックは、世田谷区にあり三軒茶屋駅から徒歩1分のところにあります。成人矯正では短期間でなるべく痛みの少ない方法で、矯正を行っています。カウンセリングルーム...

-
- ハル薬局なら医療用葛根湯が通販で買える
- 寒い季節になると風邪をよく引く人を見かけ中にはインフルエンザでつらい思いをされる人も増えます。それだけでなく季節の変わり目には寒暖差が大きくなり、風邪を引いてしまった、あるい...
-
- 白金高輪駅から徒歩1分の心療内科
- 「しろかねたかなわクリニック」は、白金高輪駅4番出口から徒歩1分の心療内科です。子どもからお年寄りまで、幅広い世代の心の治療をおこなっています。不安や焦りを感じる、落ち込みや...
-
- 歯の黄ばみはホワイトニングで解決できる
- 歯の黄ばみが気になっているのなら、池袋にあるグランドメゾンデンタルクリニックに通ってみましょう。漂白剤を用いて、歯をきれいにしてくれるので、望み通りの白さを手に入れられます。...
-
- ガミースマイル治療が得意な歯科医院
- 歯並びや歯の色で悩む人は少なくありませんが、笑ったときに歯茎が見えてしまうことで悩む人も多いものです。歯茎が見えることを気にするあまりに、人前で笑顔を作れないという人もいるの...
-
- 豊田市のクリニックが提供している皮膚科
- 愛知県豊田市の井上医院は、平成18年3月1日に開院した医療機関で、笑顔のある医療をモットーとして皮膚科・内科・小児科・リハビリテーション科と様々な診療を提供しています。また、...

-
- 歯周病かもしれないなら歯科医院へ
- 歯を磨いている時に、血が出たことはありませんか。別に痛みがあるわけではないのに、一体何があったのだろうと不思議に感じたことがあるかもしれません。コマーシャルでチラッと見たこと...

-
- 審美歯科できれいな笑顔と美しい歯に
- きれいな笑顔は、周囲の人から好感を持たれ良い人間関係づくりに欠かせないものです。しかし、口元から見える歯並びや歯の色が悪ければ、その笑顔の魅力も半減します。また会話するときに...

-
- 有田郡であるささの歯科クリニック
- ささの歯科クリニックは有田郡で営業しているクリニックです。診療時間は月曜日から土曜日の9:00から12:00と、月曜日から金曜日の14:00から19:00です。日曜日と祝日は...
-
- 宇都宮にある地域密着型の胃腸科
- 宇都宮で、優れた技術と丁寧な診療を行っている胃腸科を探しているという方は斎藤内科医院を利用してみてはいかがでしょうか。斎藤内科医院では、最新の医療設備を活かした診療を行ってい...
-
- 審美歯科表参道デンタルクリニックの値段
- ふだん生活をしていて、もっと歯並びがよかったら良いのにという事はありませんか。街を歩いていても綺麗にお化粧をしているのに歯並びが悪くて残念な人を時々見かけます。特にお年頃の方...

-
- 三重県でインプラント治療を行うなら
- 加齢や虫歯が深く進行してしまったり不意のトラブルなどで歯が無くなってしまった時の治療方法として、インプラント治療を行うと日常生活の上で自分の歯と同じ感覚でトラブルもない事から...

-
- 人工透析のオアシスメディカルの魅力とは
- オアシスメディカルは、人工透析を受けている人が生き生きと生活できるよう、さまざまなサポートを行っている透析医療クリニックです。患者の生活を第1に考え、在宅人工透析について知っ...
-
- 目立ちにくい矯正治療を行っている歯科
- 名取市に生活している方も口内の治療を受けることができる矯正歯科のサイトになります。少しでも矯正治療中の負担を減らす事ができるように目立ちにくい矯正治療を実施しています。歯の裏...

-
- 甲状腺疾患の検査と治療ができる病院
- 所沢市には甲状腺疾患の検査と治療ができる病院があります。今城内科クリニックは甲状腺疾患や糖尿病、肥満などの代謝疾患を診察しています。一般内科や生活習慣病も診察内容に含まれます...

-
- インプラント治療の環境が充実した医院
- 一般的な虫歯治療とは違って、高度な技量が求められる外科手術も伴うインプラントは、医師のスキルもさることながら医療機器や感染症対策など、手術が安全に遂行できる設備環境も充実して...
-
- 鹿島田駅近くの土日診療を行う審美歯科
- 川崎市幸区新川崎にある新川崎グレイス歯科では、一般歯科や小児歯科はもちろん、歯周病予防・歯周病治療・予防歯科・歯科口腔外科・矯正歯科・審美歯科・無痛治療というように、幅広い診...

-
- 袖ヶ浦で補聴器のことが相談できる
- 耳が聞こえにくく困ったと感じたときに袖ヶ浦の補聴器専門店なら役立てることができます。経験豊富なスタッフが在籍をしていて、気軽に相談をすることができます。カウンセリングを重視し...

-
- 金沢市で複視の症状でお困りの方へ
- 複視とは物が二重、三重に見えることを言います。見づらいというだけでなくやはり何が原因か心配になってくるでしょう。金沢市小坂町にあるおおくぼ眼科クリニックは東金沢駅東口前に20...

-
- 不安のない矯正治療で理想の歯並びに
- 多くの方が不安に感じるのが矯正治療です。目立つ装置を装着しなければならない上に、虫歯や歯周病を患うリスクもあります。さらに強い痛みを感じることもあり、気軽に治療を受けることは...
-
- インプラントのことなら高崎の歯医者へ
- インプラントを検討しているなら、高崎にあるCICクリニカルインプラントセントラム石倉歯科医院に頼ってみるのが良いでしょう。初めての人の中には、手術をすると聞くと痛みがあるので...

-
- 評判の良い肛門外科が新潟にある
- 痔に悩んでいる女性が増えていると言われています。しかし、部位が部位なので恥ずかしさが先行し、なかなか病院を受診できないという人も多くなっているのです。そんな人におすすめなのが...
-
- いつでも頼れる街の歯医者さんがある
- 「すずき歯科」は、清水区の頼れる街の歯医者さんです。通いやすい歯科医院を目指しており、小児歯科なども取り扱っています。院内の受付・待合室も、歯科医院らしくない見た目となってお...

-
- 静岡県静岡市清水区での小児歯科治療なら
- 静岡県静岡市の清水区において、小児歯科治療を行ってもらえる歯科医院を探しているのなら、「すずき歯科」を選んでみてはいかがでしょうか。「すずき歯科」は清水区駒越に構える歯科医院...

-
- 馬車道駅から1分逆流性食道炎の治療は
- 逆流性食道炎とは、食べた物が胃酸と共に逆流することにより、食道の粘膜が炎症状態になることを言います。胃液には酸性度の強い塩酸(胃酸)が含まれており、食物の中に含まれるタンパク...

-
- 綺麗にタトゥーを消したいと思うなら
- 近年では我が国においても、外国人のようにタトゥーを入れている人も増えていますが、やはり、タトゥーに対してのイメージはあまり良いとは言えず、様々な障害を感じることになり、入れた...

-
- 奈良において婦人科を受診したいときには
- 奈良にて婦人科を受診したいなら、医療法人クリニカ・ドンナ洋子レディースクリニックです。ここは女性専用のクリニックなので、初めて来院をする場合であっても緊張をすることなくリラッ...
-
- 千葉県で開院している産婦人科です
- 子孫を残す出産は、女性が備えている非常に重要な身体機能です。しかし、簡単な行為ではなく、医療技術の未熟な時代は生命の危険を伴うことが珍しくありませんでした。現代医療の普及して...

-
- 丁寧な診療が評判の八王子の審美歯科
- 審美歯科とは審美的に優れた歯の治療のことを指します。また機能性も併せ持っています。単に綺麗なセラミックの歯を取り付けるだけでは理想の治療とは言えません。八王子の歯科医院では綺...

-
- 太田母斑などのアザをレーザーで治療する
- 日本橋Fレーザークリニックはアザ、ほくろ、にきび、ウオノメなどの疾患に対しレーザー治療を実施しているクリニックです。アザには太田母斑、蒙古斑に代表される青アザ、扁平母斑である...

-
- 東京で美容歯科をお探しの人におすすめ
- 歯は全身の健康をも守るといわれており、歯を大切にする考え方が浸透してきていますが、虫歯などの歯の健康だけでなく、噛み合わせや見た目も身体面、精神面に影響してくるものです。仕事...
-
- 歯周病治療にアース歯科クリニック
- 都営三田線板橋本町駅より徒歩30秒のアクセス便利な歯医者が、医療法人社団ユニバースのアース歯科クリニックです。各治療分野の複数医師が在籍し、チーム医療により一般からインプラン...

-
- 広島市で不眠症の治療をしたいなら
- 広島市において不眠症の治療をしたいときには、立町クリニックを受診することです。ここでは経験豊富な専門医が診療を行っているので、普段人に相談できないことも気軽に話せると評判にな...
-
- 幅広いアドバイスをしてもらえます
- 糖尿病の方は広島市の本通トータルヘルス内科クリニックで相談しましょう。糖尿病治療は運動療法をはじめ食事制限や投薬療法が中心です。ただ生活習慣により症状が大きく左右されるため、...

-
- より良い品質のインプラント治療
- 「健康で美しい歯は、心身の健やかさと幸福な人生をもたらしてくれる」をモットーとして治療を行っている歯科医院が千葉県柏市にあります。その名前は「審美インプラントセンター柏 田中...

-
- 今までの常識を覆す最先端技術で歯の治療
- 従来の歯科医師が肉眼で虫歯をチェックして麻酔を削る歯の治療方法から最新機器や技術を用いるようになり歯の治療も大きく変わりました。最先端の治療では虫歯、歯周病の予防にレーザーを...
-
- 板橋で矯正歯科ならアース歯科クリニック
- 板橋区大和町にある医療法人社団ユニバースのアース歯科クリニックは、一般や矯正からインプラント等まで歯科領域全般の診療を扱う歯医者です。各治療分野の歯科医師が複数在籍し、歯のこ...
-
- 審美歯科で行われている治療方法について
- 審美歯科というのは、虫歯や歯周病の治療とは異なっています。口の中の状態を改善するというよりは、見た目を美しくするという点に力を入れています。松本市ではこの治療に力を入れている...
-
- お手頃なインプラントの費用とは
- インプラントの治療を行うなら、神奈川県相模原市にたかしま歯科があります。たかしま歯科ではインプラントは5種類コースがあり、費用はそれぞれ異なっています。POI1ピースは1本1...

-
- 患者さんの希望も考慮している治療
- 豊四季駅から徒歩で10分の「すがや歯科クリニック」は、待たすことのない診療や痛みを感じないように行う丁寧な治療、わかりやすい説明の3つを掲げながら日々の診療が行われています。...

-
- 成城での審美歯科の受診について
- 審美歯科とはその名の通りに歯科の一種で、歯の見た目を美しく整える事を目的とした歯科の事を言います。歯は顔のパーツの中でも特に印象に残りやすいので、この部分を綺麗にする事で少な...

-
- 最新機器を使用した高い技術の治療なら
- インプラント治療は自費診療のため、それにかかる価格は歯科によって異なります。そんな治療費をホームページで公表しているのが、うすい歯科医院です。郡山に開院している歯医者で、イン...

-
- 小田原でおすすめしたい歯科医院とは
- 伊藤デンタルクリニックは神奈川県小田原市にあり、おすすめの歯科医院です。2016年に移転しており、院内は広くて清潔です。治療室は10室もあるため、待ち時間も短く治療に入れるこ...
-
- 負担が少ない中絶手術をする病院
- 御苑前ウィメンズクリニックで受けられる中絶手術は、患者への負担を軽くするために無痛での手術を実施している他、入院せずに帰宅した方の希望に沿った日帰り手術の実施を進めています。...
-
- 越智歯科昭和町医院の審美治療について
- 福山市にある越智歯科昭和町医院では、歯の色が気になっていたり、詰め物や被せ物を自然な色にしたい、歯並びを美しくしたいなどの悩みを抱えている人のためにホワイトニング治療や審美治...

-
- レーザー治療なら「とし歯科医院」
- 八王子にある「とし歯科医院」は、痛くない、怖くない歯医者を心がけながら対話を重視して治療を行ってくれています。患者さん一人ひとりのライフスタイルも考慮してくれて設備に関しても...

-
- 辛くない胃カメラが受けられるクリニック
- 胃カメラってものすごく苦しくて苦手だと言う人も多いのではないでしょうか。大船にある信愛クリニックの胃カメラは、非常に患者様からの評価が高いというのをご存知ですか。その理由は、...

-
- 歯の色で悩んでいるなら審美歯科で相談を
- 歯が黄色かったり黒ずんだりしていることで悩んでいる方は多いかと思います。しかし、毎朝鏡の前で自分の歯を見るたびに落ち込んでいても、根本的な解決にはつながりません。そのような悩...

-
- 京都にある見えない矯正を知りたい方へ
- 大人になって矯正をするとなると見えるのが恥ずかしいと思ったり矯正したいけどでもっと迷う方もいます。京都にある「あおい矯正歯科」では成人の見えない矯正。を行っています。見えない...
-
- 大阪で看護師の求人を探しているなら
- 看護師の仕事を大阪で探しているという人におすすめのサイトがあります。医療法人錦秀会の採用情報サイトです。医療法人錦秀会は、阪和記念病院や阪和住吉総合病院などたくさんの病院・施...
-
- 堺市で審美治療を受けるのであれば
- 堺市内に住んでいる方で美しい口元を手に入れたい、と思っているなら、1度「田中歯科医院」を訪れてみると良いでしょう。ホワイトニングやラミネートベニア、セラミックインレー、オール...
-
- 医療ウェアを通販サイトで購入しよう
- 「ホワイトマックス社」は、白衣などのドクターウェアや、ワンピースなどのナースウェア、介護ウェアやエステウェアなどの幅広い医療ウェアを購入することができる、便利な通販サイトです...

-
- 葛飾区で循環器科のあるクリニック
- 葛飾区で循環器科のあるクリニックだったら、ハートクリニックがオススメです。血液の循環に影響する心臓疾患や高血圧の治療や、狭心症や心筋梗塞など、また先天性の心臓病などの検査や治...
-
- 船橋にある歯医者は頼りがいがあります
- 京成船橋駅から徒歩5分のところにあるオリーブ歯科クリニックは、地域に根差した歯科クリニックとなることをモットーに診療を行っています。そのため、夜も9時まで診察を行うなど、会社...
-
- 神奈川県の新川崎グレイス歯科について
- 新川崎グレイス歯科は、神奈川県川崎市幸区にある歯医者さんです。新川崎駅直結のシンカモール3階に展開しており、買い物の途中や仕事帰りの方でも大変利用しやすい場所に位置しています...

-
- お洒落な元町・中華街エリアの歯医者
- みなとみらい線の元町・中華街駅から徒歩4分くらいのところに位置しています。平日も土曜日も午後8時まで営業しているので、平日にどうしても仕事や習い事などで診察を受けに行けない場...

-
- 夜間透析が人気のクリニックについて
- 現代では、患者が利用しやすい医療機関が高い人気を誇っています。小牧市内にあるクリニックでは、糖尿病内科や人工透析などに対応していて地域住民たちからも親しまれています。日中はな...
-
- 堺泉北インプラントセンターは厚く信頼されています
- 歯を失ってしまうと、不便でなりません。体全体への影響も大きく、食べものを噛むことができないところから、健康にもマイナスをもたらすことが多いです。昨今は、...

-
- 守口市の地域密着の歯科医院の概要
- 守口市にある三浦歯科医院は、最新技術を導入して治療と予防に積極的に取り組んでいる点が特徴的です。とりわけインプラント治療に力を入れており、治療後のメンテナンスも丁寧に行ってい...

-
- 歯を綺麗にするインプラントとは
- 今や歯を綺麗に見せる時代が到来していこう多くの著名人・芸能人が行っているのがインプラントです。インプラント治療はもともと持っている歯に対してネジを埋め込み人口的に作った綺麗な...

-
- 武蔵野市での産婦人科ならこちら
- 武蔵野市で産婦人科を探しているなら、こちらがおすすめです。とてもきれいで清潔感あふれる院内となっています。キッズスペースがあるので子供連れでも安心して通うことができます。何で...
-
- 赤坂ヒルズ整骨院で肩こりの解消
- 今の時代は、仕事でパソコンを利用する人がとても多くなってきています。パソコンを長時間にわたって使用していると、目がとても疲れやすくなりますし、さらには肩こりとか腰痛に発展した...
-
- 表参道の歯科について分かりやすく説明します
- 表参道の歯科について分かりやすく説明します。根管治療や無痛治療をしているし、ハイブリッドインレーやハイブリッドクラウンやセラミックインレーやセラミッククラウンを用いた治療をし...

-
- 女性が輝く毎日を送るお手伝いをします
- 高崎市にある「こすもレディースクリニック」は平日夜遅くまで診療している産婦人科です。妊婦検診はもちろんのこと、更年期障害の軽減、母乳トラブルに対しての相談、ベビーマッサージ教...

-
- 都内で心療内科をお探しならこちらです
- 都内で心療内科をお探しなら、千代田心療クリニックがおすすめです。最寄り駅の永田町駅より徒歩1,2分ですのでアクセスも便利です。千代田心療クリニックはうつ病からパニック障害、自...
-
- 沼田市で産婦人科を受診しようとしている女性は
- 沼田市で生活されている女性の皆さんの中には、産婦人科を受診しようとしている方もいる事でしょう。そんな方たちにおすすめするのが塩崎医院です。何故ここをおすすめするのかというと、...
-
- 開業してから31年診療を行っている西新宿の歯科です
- こちらは西新宿都庁の前にある歯医者で、虫歯や歯周病などの歯の痛みの悩みを解決します。この歯科医院では、最新の医療技術を積極的に取り入れている病院で、さらに患者の歯の健康を総合...

-
- 虫歯のつらさを軽減してくれる北九州の歯科
- 歯磨きを怠ったり、生活習慣が乱れるとなってしまうのが虫歯です。身近だけれどもとても嫌なものです。その証拠に、昔から虫歯を削るドリルの音は、人の心をかき乱すものとして扱われてい...

-
- 市原市の高宮ガーデン歯科クリニックについて
- 市原市の高宮ガーデン歯科クリニックは歯周病や矯正治療など口腔内のいろいろな治療を行っている歯医者です。歯周病治療においてはパーフェクトペリオと呼ばれる口腔機能水が使われていま...
-
- 新所沢駅からすぐの内科のご案内
- 内分泌疾患には主にバセドウ病、橋本病、甲状腺腫瘍などあります。これらの病気は内科を受診しますが、所沢市にある、「今城内科クリニック」は内分泌や糖尿病など代謝疾患専門の内科とな...
-
- 神奈川県川崎市にある「三島眼科医院」のご紹介
- 「三島眼科医院」は、神奈川県の川崎市のJR南北線「武蔵溝ノ口駅」または東急田園都市線「溝の口駅」から徒歩1分という駅前の大変アクセスの良い場所にある眼科医院です。診療時間は月...
-
- 禁煙外来のある千葉の病院について
- 禁煙外来を設けて禁煙に向けての試みをサポートするのが、西千葉整形外科です。この病院は保険診療で禁煙のための様々な治療が受けられるのが特徴で、呼吸器の検査などを通じて肺の状態も...

-
- 福井には確実なインプラントを行う歯科があります
- 一般的な歯医者さんとは違った、キメの細かい丁寧な治療を実践している歯科が福井にあります。特にインプラントに関しては患者の立場に立った利便性の高い施術や治療を行っている事をご存...

-
- 安心して生活出来る群馬の住宅型有料老人ホーム
- 安心して生活出来る群馬の住宅型有料老人ホーム、安価で快適に生活できる施設です。利用者の意見に耳を傾けてくれるので、その人に合ったサービスを提供して貰えるのが良い点です。小さな...

-
- 患者目線の治療を行う歯医者が笠原歯科です
- オーラルケアを重視して治療を進めているのが、人形町・日本橋・六本木・蔵前・千川にある笠原歯科グループの歯科医院です。知恵のシンボルとされている、ふくろうをモチーフに取り入れた...
-
- アクセスしやすい足立区の出産できる病院
- 初めての妊娠、出産は分からないことばかりで、悩みを抱えがちかもしれません。人生で何度も経験できることではないので満足のいく出産をしたいと、いろいろと調べてから病院に行く人も多...
-
- 他の歯科医院で断られた方も診察してもらうべき
- インプラントの治療の流れは、レントゲンによる診断から始まります。インプラントを希望する患者様のなかには、心臓病や、糖尿病などの持病を持っている患者さんや、妊娠中の方や、顎の骨...
-
- 糖尿病を見てくれる専門の医院です
- 三重県津市にある「赤塚クリニック」は内科や消化器内科、消化器外科や乳腺外科、外傷外科などの外科の他に糖尿病内科があります。糖尿病内科では病と立ち向かう方の教室や家族へのアドバ...

-
- 静岡で頼りになるのはリモーネ矯正歯科です
- 歯のトラブルを抱えた時に頼れる存在となるのが、静岡県にあるリモーネ矯正歯科です。リモーネ矯正歯科で治療を受ける事により、歯並びや虫歯などを改善する事が可能となっています。歯並...
-
- 大船の審美歯科ならこちらがおすすめです
- 審美歯科というのは、虫歯や歯周病など歯の噛むといった治療だけでなく、歯の美しさや見た目にも着目した治療法のことで新しい部門です。神奈川県鎌倉市周辺でこの審美歯科をお探しの方で...
-
- 整形外科の役割と今後への期待とは
- 高齢化社会の到来により、整形外科の重要性も大きくなってきました。リハビリや緩和ケアなどを行うその役割には、大きな期待が寄せられています。そんな中において、千葉にある、西千葉整...

-
- 京都市北区の矯正歯科なら利用しやすい所があります
- 京都市北区には歯科医院が複数あり、利用する所によって差があります。差が付いている点は複数ありますが、対応が良い所を選べば損をする事が無くなります。京都市北区で矯正歯科を選ぶ時...

-
- 藤沢市でおすすめの歯医者さんについて
- 神奈川県藤沢市で歯医者さんが探している人に朗報です。ともき歯科クリニックという歯医者さんがあります。ここでは、一般歯科、小児歯科、口腔外科、予防歯科といったものから、今話題の...
-
- 熊本市周辺で産婦人科を探している人にお勧めです
- 妊娠がわかり産院を探さなければいけないが、どこの産院に行こうか迷っているという人にお勧めの産院があります。その産院は熊本市にある”ゆのはら産婦人科医院”です。こちらの産院は、...
-
- 安心してインプラントを受ける事が出来るジェイズ歯科
- 茨城県水戸市にあるジェイズ歯科は、痛くない治療、徹底した滅菌を行い、院内感染等の対策に重点を置く歯科医院です。歯医者と聞けば、痛いというイメージがありますが、このイメージを根...
-
- これから堺市で転職を考えるならば
- 今のような時代であれば、転職をすること自体、誰でも行っていて、当たり前のような時代になっています。では、これから堺市で看護師転職を希望する人は、どんな手段で転職を検討していく...

-
- 安心して審美歯科治療を受けるなら小幡歯科クリニック
- 小幡歯科クリニックは京都市南区にある、歯科クリニックです。虫歯や歯周病などの一般歯科治療の他にも、審美歯科治療も行っています。京都には審美歯科治療を行っている歯科クリニックは...

-
- 矯正に対するイメージを変えた北九州の矯正歯科
- 矯正歯科といえば、痛いとか時間がかかるというイメージが強く、歯並びや噛み合わせが気になっていても歯科医院から足が遠のいてしまう人もいるでしょう。痛みが少なく短い期間で矯正が完...

-
- 神戸で脳神経外科クリニックをお探しなら、ここへ
- 今後、ますます高齢化が進む日本では、健康問題がますます重要なテーマになっています。多くの疾病の家、脳疾患が大きな位置を占めています。脳疾患は、発症すると生命の危険があると同時...

-
- 高性能の機械を取り入れているながい歯科クリニック
- 日吉にある「ながい歯科クリニック」は、清潔感のある待合室、診察室でリラックスできます。ながい歯科クリニックは、キッズルームも設けているそうです。本やおもちゃが充実しているので...
-
- 大宮で産婦人科をお探しの方はこちらです
- 大宮駅近くの閑静な住宅街にあるおすすめの産婦人科で、妊娠から分娩、出産後にわたるまで親身になってサポートしてもらうことができます。こちらの大宮林医院では、リラックス効果の高い...
.jpg)
-
- 六本木で地域に根ざしたインプラント技術が高い歯科
- 蔵前、人形町、千川、日本橋、六本木地区で診療を行っている笠原歯科グループは地域に根ざした診療をモットー出来るだけ丁寧な説明と、痛くない治療を実践しています。国立東京医科歯科大...
-
- 青森市にある歯科甲子園D1グランプリ優勝医院とは
- 青森市緑にあるミドリデンタルクリニックは、第2回歯科甲子園D1グランプリで優勝したクリニックです。歯科甲子園とは、患者への気配り・心配り・言葉遣い、技術の研鑽、衛生面や消毒な...

-
- 北九州市で評判の矯正歯科治療を受けられるのは
- 歯並びの良さは、他人に与える第一印象を大きく左右します。歯並びの悪さがコンプレックスで、人前で口を開けることに抵抗がある人や、口元を手で隠してしまうという人も多いです。矯正歯...

-
- 耳鼻咽喉科などを扱っている春日井にあるクリニック
- 春日井にあるこちらのクリニックでは、耳鼻咽喉科や内科などを扱っています。耳鼻咽喉科では、睡眠に関する症状や耳鳴りなどの治療を行なっています。耳鼻咽喉科や内科などの診療の他に、...
-
- 初めてのペットにも安心な京都市の動物病院
- 初めてペットを飼う場合には、いろいろな不安を感じる場合が多くあります。それは、躾や病気に関することなどから始まり、日常生活においての接し方など様々です。動物は小さな内はとても...

-
- 「よしだファミリー歯科」について
- 「よしだファミリー歯科」は、新潟市江南区にある歯科医院です。亀田駅から県道2号線沿いの「曽野木連絡所」バス停から徒歩1分の所にあり、駐車場も完備されていますので車で通院するこ...
-
- 北九州市八幡西区で歯のことなら何でも相談できる歯科
- 北九州市八幡西区にあるHANAデンタルクリニックは、地域のかかりつけ医を目指して一般・矯正・小児歯科、口腔外科、インプラント治療を行っています。中でも一般歯科では矯正・小児、...

-
- 自転車通勤保険は備えになります
- 自転車通勤保険は自転車を利用している間に発生した事故や怪我などに対し補償を行う損害保険です。年間保険料は比較的安価で済み、他人に怪我をさせた場合の損害賠償を補償する保険になっ...











































































































































